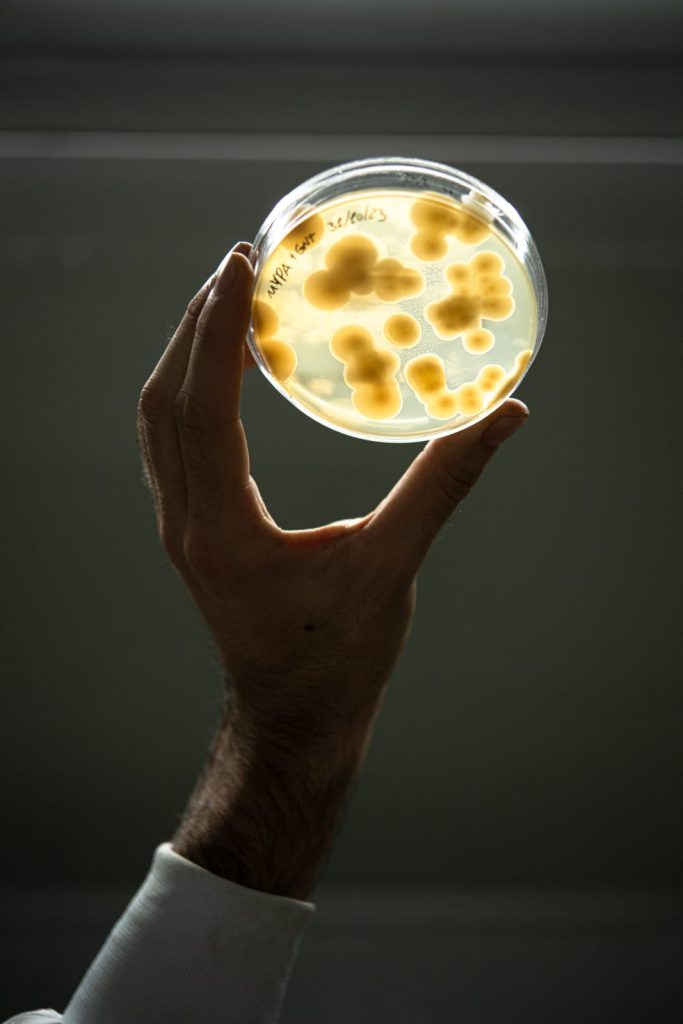

"אם היער היה מתכון לעוגה אז הפטריות והתפטיר היו הביצים".
גיליאנה פורצ'י ((Giuliana Furci מייסדת Fungi Foundation, מיקולוגית מצ'ילה
בשנים האחרונות אני מאד מחוברת לנושא התפטיר, גוף הפטריה, בהקשרים רבים ובמיוחד בהקשר אמנותי. התפטיר הוא יצור מדהים, עם תכונות מופלאות ונדירות, ואני מרגישה שליחות של ממש להכיר לעולם את התפטיר. לא כולם יודעים שהתפטיר יכול לצמצם את הפסולת והזיהום ברחבי הגלובוס אם התעשיות הרלוונטיות יכירו בו ויעשו מאמץ להשתמש בו בפרויקטים אקולוגיים בתחומים שונים. החלטתי לקחת תפקיד בחשיפת התפטיר לבני האדם: בפרויקט האמנות שאני יוצרת בימים אלה בנושא התפטיר אני מדגישה את המילה הזו, הלא מוכרת, בעזרת יצירת הלחמי מילים עם המילה תפטיר כדי "להוציא אותה לאור" מזווית נוספת: "שפתפטיר" (שפת תפטיר), "צמיחתפטיר" (צמיחת תפטיר) ועוד ועוד.
כדי לעזור לכם להכיר את התפטיר ואת חשיבותו, שוחחתי עם עמרי מגיד, בעל חוות הפטריות "יער פטריות אקזוטיות", עם המעצבת כליל אתרוג שיצרה מיכל שמנגיש את גידול הפטריות לקהל הרחב, ועם המדען ד"ר רזי הופמן, ביולוג ימי ומנהל אוספים בוטניים באוניברסיטת ת״א, כולם עזרו לי להבין למה התפטיר הוא יצור סודי כל כך, לא מוכר ומסתורי.
תפטיר – הגוף של הפטריה, לא השורש שלה
ההגדרה הכי מעניינת בה נתקלתי עבור התפטיר היא "גוש חוטים" – מדובר ביצור עתיר קורים דקיקים שנמצא בדרך כלל במעבה האדמה. שתי עובדות אלה – דקיקות הקורים והימצאותם במעמקי האדמה, רחוק מהעין האנושית, גרמו לתפטיר להיעלם מעין הציבור. גם מי שעובד עם התפטיר לא מנגיש לציבור את המידע החשוב על התפטיר, אלא מספק מידע על ה"פטריות" שהן הפרי של התפטיר. התפטיר יכול ללמוד ולהשתנות, להסתגל לתנאים חדשים במהירות ויכולת הפירוק שלו ייחודית. עצם קיומו קריטי לשלמות המערכת האקולוגית בכדור הארץ. בנוסף, יש לחלק ממיני הפטריות – גוף הפרי של התפטיר – תכונות רבות כמו יכולות ריפוי מדהימות והן סופגות ומפרקות רעלים בפני עצמן.
למרות כל סגולותיו של התפטיר, יש חוסר התייחסות עקבי לתפטיר כיצור בפני עצמו. להמחשה, במספר מוזיאוני טבע בהם ביקרתי לא מציגים תפטיר כחלק מהיצורים בטבע, לצד כל הפוחלצים והדגמים של היצורים שבים ומעל האדמה. כתוצאה מכך, הקהל הרחב לא מכיר את התפטיר על יכולותיו המופלאות.
עמרי מגיד: "אנו, בני האנוש, מתייחסים לאוכל שלנו ומה מביא את האוכל בלבד. התפטיר לוקה בחוסר אטרקטיביות כי רובו מצוי מתחת לאדמה וגם אם אנו נתקלים בעובשים – לימדו אותנו שזה מסוכן. גם לימדו את הציבור המערבי, סביב שנות ה-50, שפטריות הזייה מסוכנות. לא ייחסו חשיבות לתפטיר. בשנות ה-50 חוקקו בארה"ב חוקים נגד הפטריות ועשו להן מיתוג רע. לעומת זאת, הפניצילין, ממנו מייצרים אנטיביוטיקה, קיבל את כל התהילה. מוסר כפול".
מגיד מוסיף שבארץ אמנם יש מיקופוביה (פחד מפני פטריות), אך בתקופת הקורונה חלה תפנית, כשהתפתחה התלהבות לליקוט פטריות. בארץ, רק מי מי שמכיר את הפטריות מכיר את התפטיר ואת תכונותיו, אבל באירופה, בארצות הברית ובמזרח אסיה תחום ליקוט הפטריות מפותח הרבה יותר ואפילו מלמדים בבית הספר על התפטיר.
התכונות המופלאות של התפטיר
"המדענים הבינו לאחרונה שלכל פטריה יש תפטיר עם תכונות אחרות ושונות לחלוטין בהרכבן. לחלק מהתפטירים יש יכולת התאמה לסביבה, ומה שהכי מרתק זה שיש עוד המון מה ללמוד ולגלות. לדוגמה, תפטיר יכול להיות טורף: התפטיר בונה מלכודות ליצורים חיים. כמה סוגי תפטיר של פטריות "קורדיספס" גורמים ליצורים כמו נמלים להפוך לפטריות ולהפיץ את הנבגים. יש סוגי תפטיר שגורמים לנמלים ולחרקים נוספים לעלות לצמרת העץ כדי להפיץ את הנבגים כמה שיותר רחוק. הנמלים נועצות את הצבתות שלהן בעץ ומתות תוך כדי התהליך", מספר מגיד.
במה מתבטאות התכונות של תפטיר הפטריה אם שינו מיקום?
מגיד: "אם נבג שמגיע ממקום רחוק ויצליח לשרוד את תנאי הסביבה, ייתכן מאוד שעבר התאמה לסביבה החדשה (תנאי אקלים, אדמה, עצים, ביום בקרקע וכו')".
נבג כזה, יש לציין, יהיה בהכרח יהיה זה אחר עם תכונות אחרות, ובמקרה זה – המותאם שורד (לא החזק שורד). באזורים השונים מאזור המקור שלו, התפטיר ייתקל בטורפים שונים, תחרות עם מינים אחרים, מחסור במזון ועוד. התפטיר שישרוד הוא התפטיר שיתאים עצמו לתנאים החדשים. לדוגמה – תפטיר מיער הגשם יהיה עמיד לגשם ולחות, ותפטיר באקלים יבש יהיה עמיד יותר ליובש. חזזיות שנמצאות מעל פני האדמה יהיו עמידות לאור השמש וינקטו בהגנות נגד טורפים, כשתפטיר שיתיישב על עץ ביער צפוף יחיה בתנאים של חושך ופחות חשיפה לטורפים.
התפטיר הוא הראשון שמפתח פטריות אחרי שריפה, אילו תכונות מיוחדות יש לו שעוזרות לו בכך?
מגיד: "טראומה כמו שריפה או סופת ברקים שמכה בתפטיר גורמת לו להתחיל לצמוח ראשון, בכל הכוח. כשהאותות הכימיים, שהתפטיר מקבל בדרך כלל מהצומח סביבו, נגמרים ואין הזנה, ינהג כמו צמח, שיפרח בזמני מצוקה כדי להתרבות, וכך יצאו פטריות. חומרים חנקתיים מזינים את התפטיר, ואז בזמני עקה (מצוקה) התפטיר צד ומשתלט על יצורים אחרים". בנוסף, התחרות עם החי והצומח מצטמצמת, וכתוצאה מכך קל לו לשגשג בהיותו חי גם מצריכת החומרים שנותרו מהשריפה.
תפטיר הפטריות – הרבה יותר מטעם טוב
התועלת שבני האדם מפיקים מתפטיר הפטריות רחבה הרבה יותר מארוחות גורמה בריאות וטעימות. למעשה, לתפטיר יש תועלת עצומה לרפואה, לסביבה ובכלל. הענף בצמיחה מהירה וישנם סטארט-אפים רבים בתחום התפטיר והמייקורמדיישן (Mycoremediation), כמו שימוש בשיטות שיקום מבוססות פטריות כדי לטהר את הסביבה. בין היתר משתמשים בתפטיר להפקה של אנזימים לתעשייה – ישנן חברות סטארט-אפ שעושות הנדסת תפטיר ויצירת מוצרים שעשויים עם אנזימים שבסיסם בתפטיר. לדוגמה, ב-15 השנים האחרונות האנזים במרככי כביסה שמפרק שומנים מופק מפטריות ומחליף חומרים הרסניים יותר לסביבה בהם השתמשו לפני כן. בנוסף, משתמשים בתפטיר בחקלאות, כתחליף לדשן שיש בו כימיקלים רבים, ומשתמשים בו גם בתעשיית התרופות – למשל, הסטטינים להורדת כולסטרול בודדו מתוך תפטיר של פטריות צדף, וכיום חוקרים גם ריפוי של מחלות חשוכות מרפא באמצעות תפטיר. התפטיר משמש גם ליצירת חומרים מבודדים, חומרים מעכבי בעירה ללא הפצת רעלים, קירור מבנים, ייצור יריעות דמויות עור, הפקת אור, ניקוי מים, זיהוי וניקוי חומרים רדיואקטיביים ועוד.
זאת ועוד, ידוע כבר משנות ה-90 שיש יותר מ-90 סוגי פטריות שמפרקות פלסטיק, אבל התחום אינו כלכלי ולכן זיהום הפלסטיק העולמי הולך וגדל למימדים מפלצתיים. "יש המון ידע על פירוק פלסטיק ונפט על ידי תפטיר, היו יכולים למצוא בתעשייה בעזרת התכונות האלה פתרונות ישימים כדי להיפטר מסוגי זיהום ופסולת ברחבי העולם. התפטיר מפרק חומרים בעצמו ויש מקרים בהם הוא מפרק חומרים בשיתוף פעולה עם חיידקים", מספר מגיד. הוא מוסיף שעוד לא גילינו הרבה ממה שאפשר ליצור באמצעות התפטיר. לדבריו, השמים הם הגבול. בנוסף, ענף תפטיר הפטריות הינו מאד חסכוני במים ומחזור הגדילה שלו מהיר – ענפי החקלאות האחרים צורכים 90% יותר. "אפילו האדמה של גידול התפטיר מועברת לחקלאות לאחר סיום גידול הפטריות ותומכת באיכות האדמה".
התקשורת בין התפטיר ובין צמחי היער
יש השערות, שהפטריות עוזרות לעצים חולים בעזרת רשת תקשורת. מערכת היחסים הזו נקראת "מיקוריזה", זהו סוג של קשר סימביוטי בין התפטיר לעולם הצומח.
האם יש רשת תקשורת מדידה שאפשר להבין אותה בחושים שלנו? שאפשר להקביל למערכת העצבים של היער?
מגיד: "אפשר למדוד אבל זה משהו אחר ממה שאנחנו מסוגלים להבין. תפטיר הפטריה מייצג את האדמה. כשאין תפטיר אין חיים. יודעים שיש איזשהו סיגנל חשמלי, שפה ושערים לוגיים. הפיצול בתפטיר הוא אקספוננציאלי, יש צמתים בהם הקורים נפגשים והמדע עדיין לא יודע איך הם מעבירים את המידע. לתפטיר יש תבונה מבוזרת ואם מנסים להאניש אותה או להבין אותה בדרך בה המוח האנושי עובד – אין בכך תועלת. הכל מפוצל למיליוני קורים ולמרות זה התפטיר מצליח ליצור תהליך מרשים של קבלת החלטות."
מגיד מוסיף, "צריך לגשת לתחום בחרדת קודש, עם יראת כבוד גדולה מאוד. הלוואי שרבים יחשבו מאיפה הפטריות באות, יחשבו מה קיים מעבר למה שאנחנו רואים על פני האדמה, מה טיב מערכות היחסים בטבע. המטרה היא שבני האדם יכירו את התפטיר ויעבירו את המידע הלאה. כיום, בונים מחשבים ביו-היברידים ומתבססים על ניסיון ליצור מחשוב מבוסס תפטיר. למחשב יש את היכולות לקחת מסר ולהחליט איזה מסר יעבור הלאה – ככל שיותר אנשים יכירו את התפטיר כך פרויקטים חשובים כאלה יתרבו".
הפטריות הן חברות, אבל חבויות
ד"ר רזי הופמן הוא ביולוג ימי ומנהל אוסף צמחי המים במוזיאון הטבע של אוניברסיטת ת"א. ד"ר הופמן חוקר אורגניזמים של מקווי מים, בים וביבשה, אף פרסם מאמר על סוג חדש עם שני מינים של פטריות שלא היו מוכרות למדע, שנקראות מרינומיקסה. "כבר מגיל צעיר מאד אספתי פטריות והתעניינתי בהן", הוא מספר.
התפטיר של הפטריה הוא יצור מדהים והינו קריטי בחשיבותו למערכת האקולוגית. למה לא מציגים את אוסף הפטריות לקהל?
ד"ר הופמן: "המוזיאון יחסית חדש, הקטלוגים לא שלמים ולא מושלמים, צריך לקדם אותם ולפרסם את הרשימות בספרות מדעית שפיטה. הנחיצות של העבודה המולקולרית גבוהה מאד, זה מאפשר מחקר טקסונומי מתקדם בו ישוו את מה שיש במאגר הידע המולקולרי מדעי העולמי ויוכלו להיות בטוחים בהגדרות ולדייק במיני הפטריות שיש בישראל". ד"ר הופמן מוסיף שמצב זה נגרם גם כי המחקר המולקולרי יחסית בראשיתו בארץ, ואף בעולם – יש תהליך של מחקר וניסוי. רק בעשורים האחרונים הבינו שהתפטיר והפטריות מהווים ממלכה נפרדת, שזה עולם ומלואו, שהם "יצורים חושבים". "צריך להנגיש יותר מידע בוטני ומיקולוגי (פטרייתי) לציבור, במיוחד מי שמגיע ל"מוזיאון הטבע" ורוצה לראות דברים נוספים מלבד זואולוגיה".
בנושא התפטיר והפטריות שמפרקות פלסטיק – ד"ר הופמן מציין שהם אינם נפוצים, הן בעצם החומר שהם מפרקים והן בפירוק שלו לבדן ללא עזרה של יצורים נוספים, "לא ידוע לפרטי פרטים מה בדיוק קורה (רב הנסתר על הגלוי) – זה כמו קסם". אומר ד"ר הופמן ומוסיף, הקורים צורכים את הפלסטיק ומקטינים משמעותית את המפגע – פלסטיק במקרה של "פסטלוטיופסיס" (Pestalotiopsis microspore), נפט במקרה של "פלאורוטוס אוסטראטוס (Pleurotus ostreatus)". נותר רק לקוות שהתעשייה תתחיל להשתמש בהקדם ביכולות המדהימות האלה על מנת לצמצם את הפסולת והמזהמים שמציפים את הים ואת אלה שנמצאים סביבנו בכל מקום.
מה התכונה החשובה ביותר לדעתך של התפטיר?
"ישנו עולם עצום ומרתק שחבוי מתחת לקרקע, התפטיר מקשר בין העצים, מעביר אליהם ומהם מידע וחומרים. ישנם סוגי סימביוזה שונים בין עצים לצמחים ולתפטירי פטריות – אפשר ללמוד על השיתוף, הקשר והתקשורת החיובית ביניהם."
ד"ר הופמן ממליץ שאנשים יכירו את התפטיר וחשיבותו, ושבמוזיאון יוצג בית גידול בו אדמת יער כבדה לחה בתוך אקווריום שמכוסה בבד שחור, ושאפשר יהיה לפתוח להסיר זמנית את הלוט על מנת להציג לאנשים את התפטיר שמתפתח בתוך האדמה.
גידול פטריות בכל בית
כליל אתרוג היא מעצבת תעשייתית שיצרה את הכלי "ג'ארה", לגידול ביתי של פטריות מאכל. אתרוג מספרת, שהמחשבה מאחורי הכלי היתה להנגיש פטריות מאכל לאנשים כמוה, שמעוניינים לגדל פטריות בבית. יש ביקוש גובר לחזרה למטבח, להעריך מחדש את העשייה הביתית והיה לה חשוב להפיץ את הבשורה של גידול פטריות בבית עם פטריות מיוחדות, וגם לתת מענה תזונתי למשפחות גדולות (משום שהפטריות גדלות מהר מאד). בנוסף אפשר לערום את הכלים ולחסוך במקום.
הכלי שכליל עיצבה עשוי קרמיקה, כדי להישאר מחוברים לפנים הבית, למטבח. המים מחלחלים אל התפטיר דרך החרס, וזה משאיר סביבה לחה בזכות תכונות החומר. זהו כד שמכיל תפטיר ולמעלה יש תעלה שבה ממלאים מים, אשר מחלחלים ועוטפים את הפטריות.
אתרוג מספרת שמאז שגילתה את הפטריות חייה השתנו והיא נהייתה מודעת יותר למזון שהיא אוכלת. עיצוב הכלי הוביל אותה למסע מענין של גילוי עצמי וגילוי של אנשים שמתעניינים בפטריות. הגילוי הזה של התפטיר מרגיש לה כמו שליחות, משהו שצריך לצאת לאור. אתרוג מספרת שהיתרון בגידול תפטיר בבית הוא נגישות. הכלי של התפטיר אסתטי והמטרה היא שהקהל ירצה להכניס אותו הביתה ולראות איך הפטריות גדלות. יש ערכות גידול של פטריות בשוק אבל מה שאתרוג מחדשת זה האסתטיקה – לגידול פטריות יש בדרך כלל נישת שיווק צרה יחסית וכאן זה מותאם לקהל יותר רחב ושלא מחפש בהכרח את הטבע בתוך המטבח, משהו יותר קליל ונקי עיצובית ופיזית.
האם נתקלת בתכונות או תגליות מיוחדות בתפטיר שגידלת?
"הפתיעה אותי העובדה שהפטריה הענקית יצאה מהחורים הקטנטנים של הכד, זה היצור שגדל הכי מהר בטבע, תוך שלושה-ארבעה ימים הפטריות מוכנות לאכילה. חשוב שיהיו אנרגיות טובות סביבו! הפטריה מגיבה. כל תפטיר הוא מיוחד. היה לי כד שנשבר והתפטיר איחה את השברים, יכולת הצמיחה שלו מדהימה. התפטיר הוא חומר חזק, גם אם יידרס – יתאחה ויצמח שוב.
תופעה מעניינת מתרחשת כשהפטריות מוכנות לאכילה: תפטיר שגידלתי בבית והאירה אותו קרן שמש, כל הנבגים התפזרו סביבו וכמו "עטפו" את הכד. נושא הנבגים מתחבר לליקוט מכיוון ששמים את הפטרייה בסלסלה עם חורים, על מנת שתפיץ את הנבגים. מענין ומיוחד לראות פטריות צבעוניות עם תכונות מעניינות – כחולות, ורודות, צהובות, הצגתי אותן ביריד האמנות "צבע טרי" והיה קיר מלא צבעים, ככל שהפטריות קולטות יותר שמש (לא ישירה) הצבע יותר חזק", מספרת אתרוג ומוסיפה שהיא חולמת שהאריזות של המוצר שלה יהיו עשויות מתפטיר.
האם העובדה שהתפטיר ייצא לאור יכולה לעזור לאנושות להרוויח מהתכונות המדהימות שלו? באיזה אופן? "כמובן שמה שאנו אוכלים מאד חשוב, לבריאות שלנו ולכל תחום. תפטיר הפטריה תורם לחיזוק מערכת החיסון וחיזוק מערכת העיכול, הוא מלא בנוגדי חימצון, ויטמינים וחלבונים – חומצות אמינו חיוניות לגוף האדם. יש לתפטיר תכונות מרפאות בתחומים רבים כמו איזון כולסטרול והאטת תהליך ההזדקנות, הוא אנטי דלקתי, אנטי ויראלי ואף אנטי סרטני".
איזה סטארט-אפים טובים וחשובים בתחום את מכירה?
"בעיקר חומרים מבודדים, כל הפולימרים במכוניות יכולים להיות מוחלפים בתפטיר שיהווה בולם זעזועים והשימוש מגוון וגם אסתטית זה יכול להתקבל ולהצליח, תאורה שעושים מהתפטיר, אחרי שמעצבים בתבניות מיוחדות, מכניסים את התפטיר לחימום, מה שעוצר את הגדילה ומשאיר אותו בצורה הרצויה, ואפשר לשחק איתו פיסולית."

: השף רותם שר, בן זוגה של כליל אתרוג, הכין מנה עם פטריות בתכנית משחקי השף של ערוץ רשת 13 | צילום: משחקי השף, ערוץ רשת 13
אז מתי כולם יכירו את התפטיר?
המצב הנתון כיום בארץ וגם בעולם הוא שיש יצור חשוב ושמו תפטיר שמתעלמים ממנו, שיש לו ממלכה טקסונומית משל עצמו בעולם החי והצומח. חמקמק ומתעתע ככל שיהיה, זהו יצור שקיים מיליוני שנים, בעל יכולות הסתגלות, למידה וקבלת החלטות ייחודיות, יכולות פירוק מזהמים שאין למצוא בממלכות אחרות בעולם החי, יכולות ריפוי עבור בני האדם, ומעל לכל, תפטירים מתפשטים לממדים עצומים, אפילו קילומטרים. מאד מוזר שאין הנגשה מצד עולם המדע של היצור המדהים הזה לקהל הרחב. נקווה שהמצב ישתנה לטובה ושהאנושות תזכה לממש את האפשרות להצלת העולם בעזרת התפטיר המדהים.
ונסיים בציטוט של המדען פול סטאמטס מתוך הסרט היפהפה "פטריה פנטסטית" (FUNGI FANTASTIC) מתוך אתר jarrakingdom-il.com:
"We’re on a mission to share the beauty & intelligence of nature, starting with the magic
.and mystery of mushrooms to protect the planet and create a better future
By making the invisible visible, cultivating gratitude and slowing down enough to be present and get curious"
Paul Stamets
אנחנו במשימה לחלוק את היופי והאינטליגנציה של הטבע, החל מהקסם
והתעלומה של פטריות, כדי להגן על כדור הארץ וליצור עתיד טוב יותר,
על ידי הפיכת הבלתי נראה לגלוי, טיפוח הכרת תודה והאטה מספקת כדי להיות נוכח ולהיות סקרן
פול סטמטס